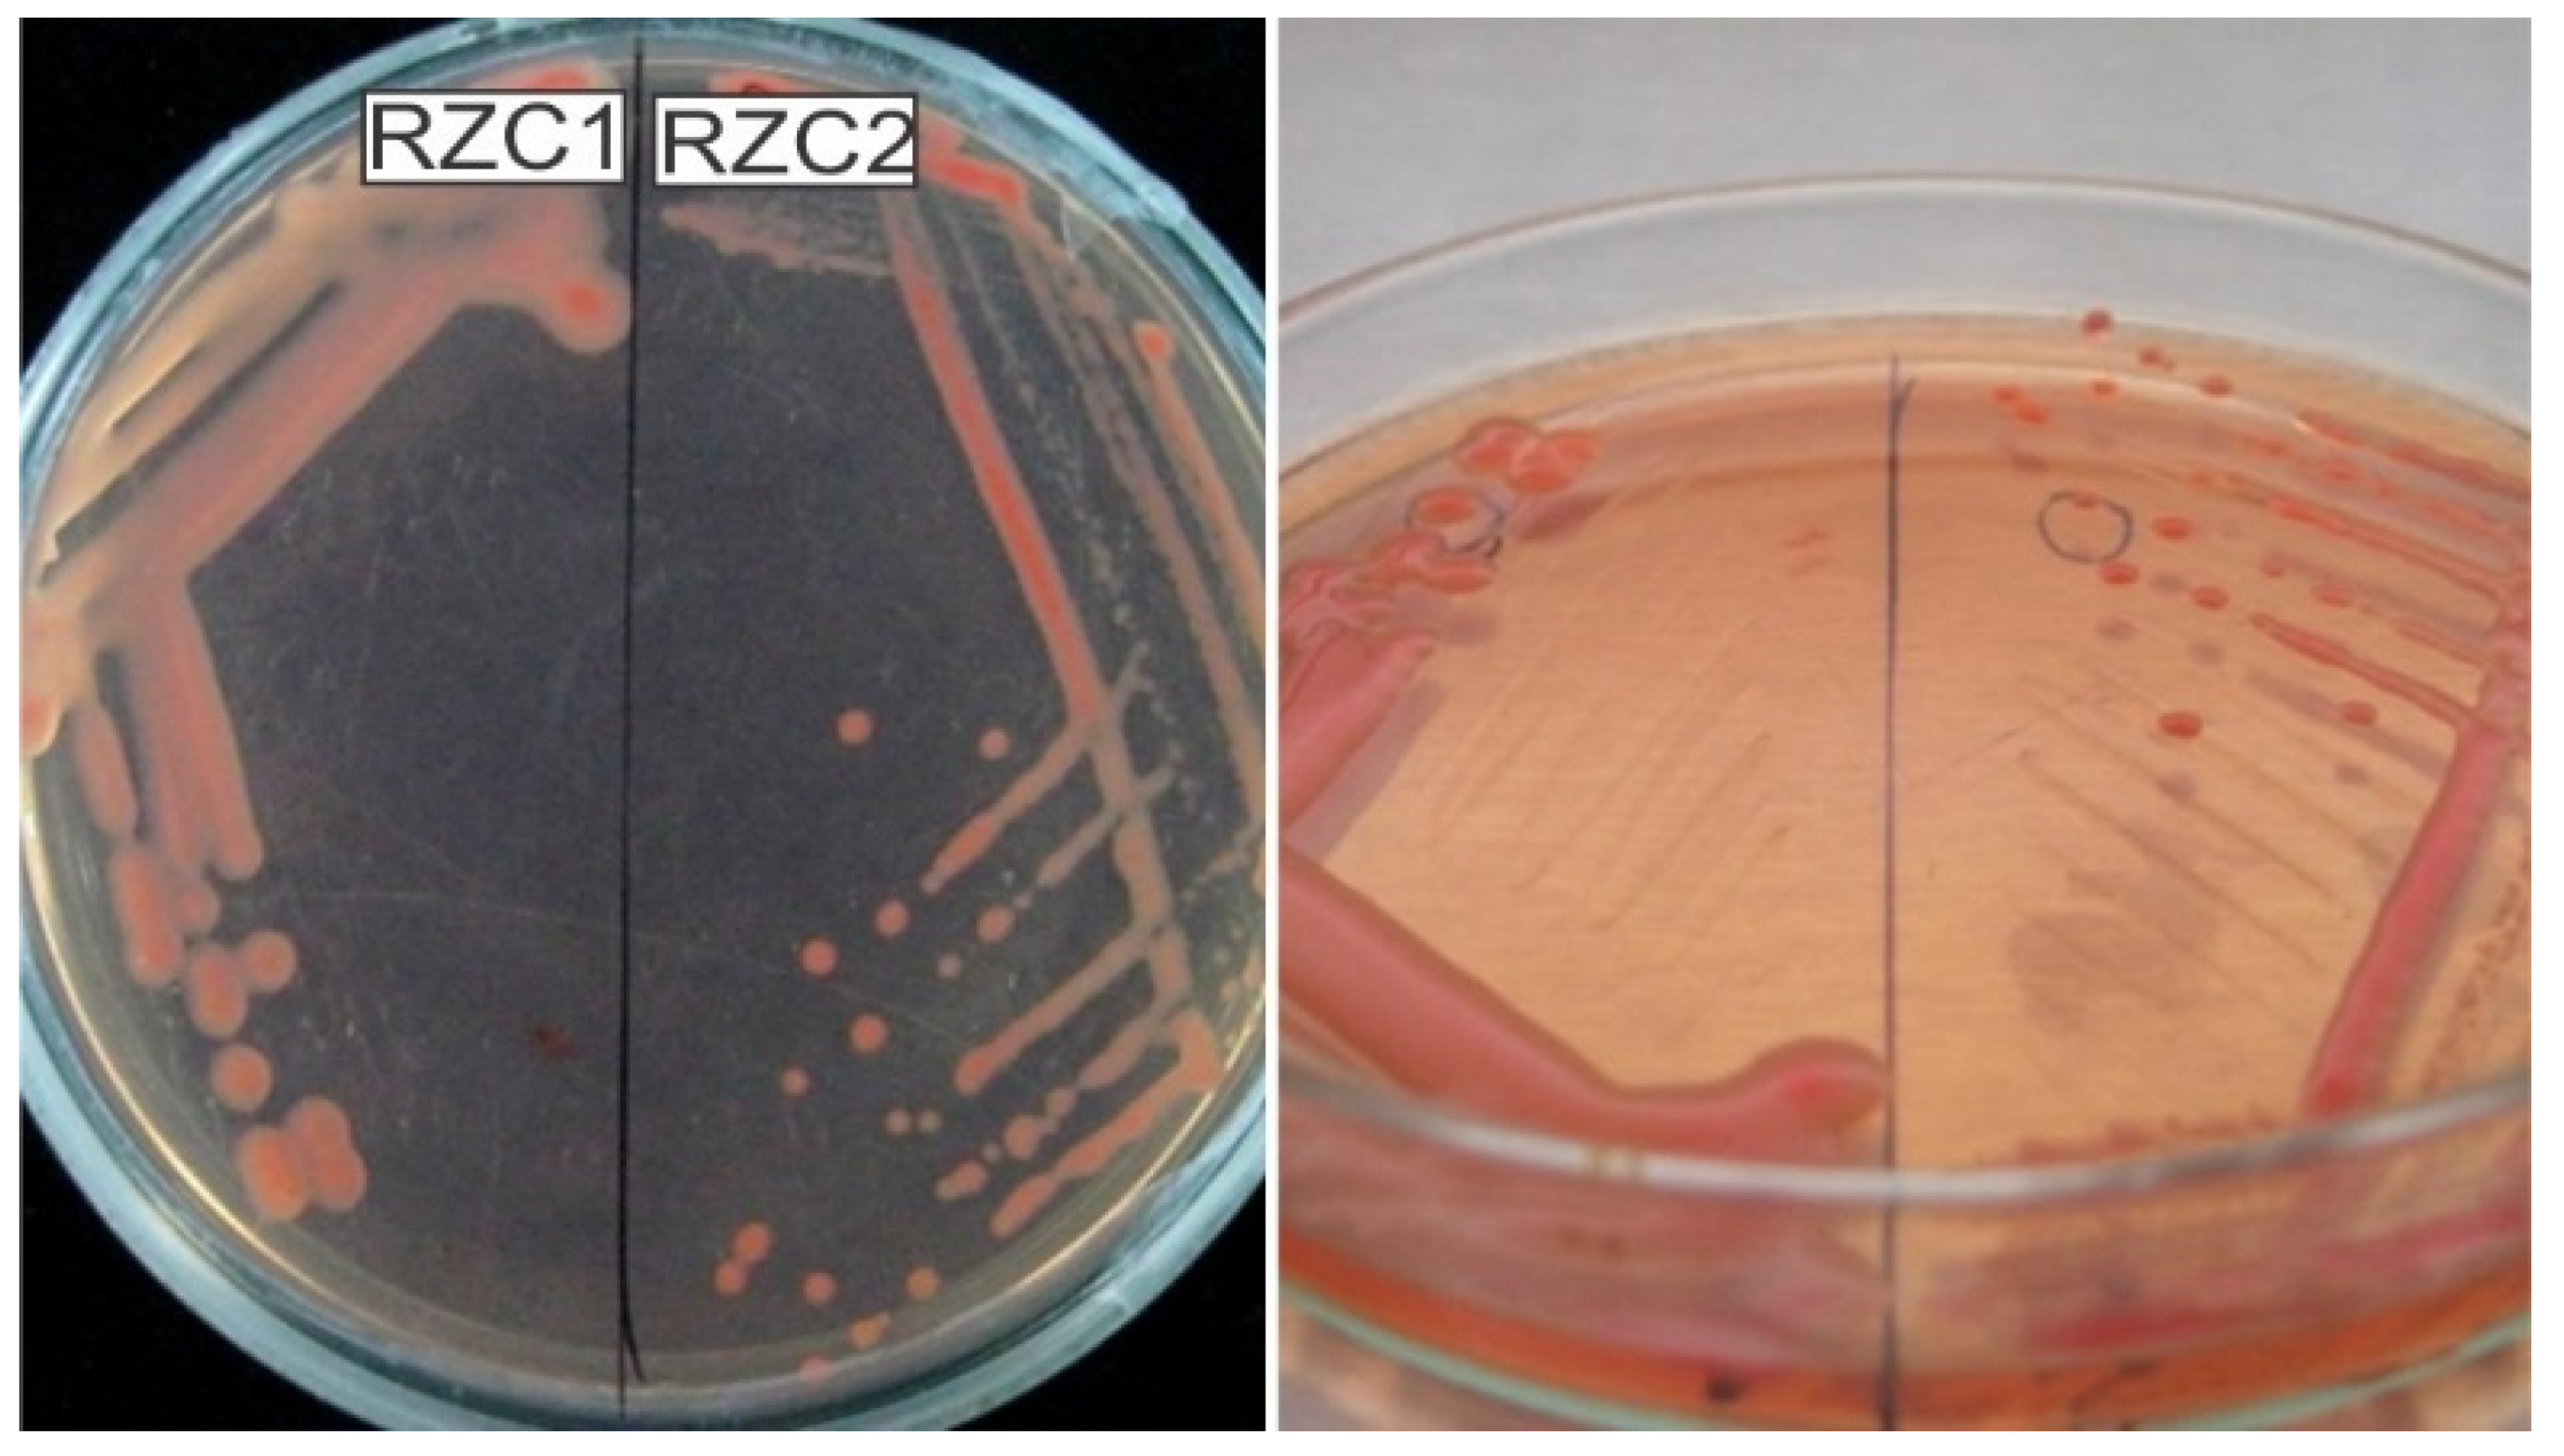
Microorganisms 10 00823 g002 Microorganisms 10 00823 g002

Effects of Rhizobia Isolated from Coffee Fields in the High Jungle Peruvian Region, Tested on Phaseolus vulgaris L. var. Red Kidney
Abstract
1. Introduction
2. Materials and Methods
2.1. Soil Sampling
2.2. Rhizobia Isolation
2.3. Phosphate Solubilization
2.4. Indole Acetic Acid Production
2.5. Rhizobia Authentication
2.6. Plant Assays under Controlled Conditions
2.7. Molecular Characterization
2.8. Field Trial
2.9. Statistical Analysis
3. Results
3.1. Soil Analysis
3.2. Isolation of Rhizobia
3.3. Plant Growth Promotion Ability
3.4. Authentication Assays
3.5. Plant Assay under Laboratory Conditions
3.6. Field Experiment
3.7. Phylogenetic Analysis of the Strain
4. Discussion
5. Conclusions
Supplementary Materials
Author Contributions
Funding
Institutional Review Board Statement
Informed Consent Statement
Data Availability Statement
Acknowledgments
Conflicts of Interest
References
- Jez, J.M.; Lee, S.G.; Sherp, A.M. The next green movement: Plant biology for the environment and sustainability. Science 2016, 353, 1241–1244. [Google Scholar] [CrossRef] [PubMed]
- Bhardwaj, D.; Ansari, M.W.; Sahoo, R.K.; Tuteja, N. Biofertilizers function as key player in sustainable agriculture by improving soil fertility, plant tolerance and crop productivity. Microb. Cell Factories 2014, 13, 66. [Google Scholar] [CrossRef] [PubMed]
- Wezel, A.; Casagrande, M.; Celette, F.; Vian, J.-F.; Ferrer, A.; Peigné, J. Agroecological practices for sustainable agriculture. A review. Agron. Sustain. Dev. 2014, 34, 1–20. [Google Scholar] [CrossRef]
- Spiertz, J.H.J. Nitrogen, Sustainable Agriculture and Food Security: A Review. In Sustainable Agriculture; Lichtfouse, E., Navarrete, M., Debaeke, P., Véronique, S., Alberola, C., Eds.; Springer: Dordrecht, The Netherlands, 2009; pp. 635–651. [Google Scholar]
- Dardanelli, M.S.; Carletti, S.M.; Paulucci, N.S. Benefits of Plant Growth-Promoting Rhizobacteria and Rhizobia in Agriculture. In Plant Growth and Health Promoting Bacteria, 1st ed.; Maheshwari, D.K., Ed.; Springer: Heidelberg/Berlin, Germany, 2010; pp. 1–20. [Google Scholar]
- Peoples, M.B.; Herridge, D.F.; Ladha, J.K. Biological nitrogen fixation: An efficient source of nitrogen for sustainable agricultural production? In Management of Biological Nitrogen Fixation for the Development of More Productive and Sustainable Agricultural Systems, 1st ed.; Ladha, Ed.; Springer: Dordrecht, The Netherlands, 1995; pp. 3–28. [Google Scholar]
- Anwar, M.R.; Liu, D.L.; Macadam, I.; Kelly, G. Adapting agriculture to climate change: A review. Arch. Meteorol. Geophys. Bioclimatol. Ser. B 2013, 113, 225–245. [Google Scholar] [CrossRef]
- Abhilash, P.; Dubey, R.K.; Tripathi, V.; Gupta, V.K.; Singh, H.B. Plant Growth-Promoting Microorganisms for Environmental Sustainability. Trends Biotechnol. 2016, 34, 847–850. [Google Scholar] [CrossRef]
- Kawaka, F.; Dida, M.M.; Opala, P.A.; Ombori, O.; Maingi, J.M.; Osoro, N.; Muthini, M.; Amoding, A.; Mukaminega, D.; Muoma, J. Symbiotic Efficiency of Native Rhizobia Nodulating Common Bean (Phaseolus vulgaris L.) in Soils of Western Kenya. Int. Sch. Res. Not. 2014, 258497. [Google Scholar] [CrossRef]
- Vargas, Y.; Valdivia, L.A. Recuperación, mediante leguminosas rastreras, de suelos degradados (ex cocales) en la Selva Alta del Perú. Mosaico Cient. 2005, 2, 78–83. [Google Scholar]
- Liu, Y.; Wu, L.; Baddeley, J.A.; Watson, C.A. Models of biological nitrogen fixation of legumes. A review. Agron. Sustain. Dev. 2011, 31, 155–172. [Google Scholar] [CrossRef]
- Santi, C.; Bogusz, D.; Franche, C. Biological nitrogen fixation in non-legume plants. Ann. Bot. 2013, 111, 743–767. [Google Scholar] [CrossRef]
- Hungria, M.; Nogueira, M.A.; Araujo, R.S. Soybean Seed Co-Inoculation with Bradyrhizobium spp. and Azospirillum brasilense: A New Biotechnological Tool to Improve Yield and Sustainability. Am. J. Plant Sci. 2015, 6, 811–817. [Google Scholar] [CrossRef]
- Allen, D.C.; Cardinale, B.J.; Wynn-Thompson, T. Plant biodiversity effects in reducing fluvial erosion are limited to low species richness. Ecology 2016, 97, 17–24. [Google Scholar] [CrossRef] [PubMed]
- Voysest, O. Variedades de Frijol en América Latina y su Origen; Centro Internacional de Agricultura Tropical (CIAT): Cali, Colombia, 1983. [Google Scholar]
- Voysest, O. Mejoramiento Genético del Frijol (Phaseolus vulgaris L.): Legado de Variedades de América Latina 1930–1999; Centro Internacional de Agricultura Tropical (CIAT): Cali, Colombia, 2000. [Google Scholar]
- Memenza-Zegarra, M.; Zúñiga-Dávila, D. Bioprospection of Native Antagonistic Rhizobacteria From the Peruvian Coastal Ecosystems Associated with Phaseolus vulgaris. Curr. Microbiol. 2021, 78, 1418–1431. [Google Scholar] [CrossRef] [PubMed]
- Zúñiga, D. Manual de Microbiología Agrícola: Rhizobium, PGPR, Indicadores de Fertilidad e Inocuidad; Universidad Nacional Agraria La Molina: Lima, Peru, 2012. [Google Scholar]
- Somasegaran, P.; Hoben, H.J. Handbook for Rhizobia: Methods in Legume-Rhizobium Technology; Springer Science & Business Media: New York, NY, USA, 2012. [Google Scholar]
- Silvester, R.; Kipe, J.; Harris, D. Simbiosis Leguminosa-Rizobio: Evaluación, Selección y Manejo; Centro Internacional de Agricultura Tropical (CIAT): Cali, Colombia, 1987. [Google Scholar]
- Vintilă, D.; Vintilă, T.; Popescu, I. Stability in real time of some cryopreserved microbial strains with reference to genetically modified microorganisms. Sci. Pap. Anim. Sci. Biotechnol. 2007, 40, 217–222. [Google Scholar]
- Nautiyal, C.S. An efficient microbiological growth medium for screening phosphate solubilizing microorganisms. FEMS Microbiol. Lett. 1999, 170, 265–270. [Google Scholar] [CrossRef] [PubMed]
- Nguyen, C.; Yan, W.; Le Tacon, F.; Lapeyrie, F. Genetic variability of phosphate solubilizing activity by monocaryotic and dicaryotic mycelia of the ectomycorrhizal fungus Laccaria bicolor (Maire) P.D. Orton. Plant Soil 1992, 143, 193–199. [Google Scholar] [CrossRef]
- Gordon, S.A.; Weber, R.P. Colorimetric estimation of indoleacetic acid. Plant Physiol. 1951, 26, 192–195. [Google Scholar] [CrossRef]
- Glickmann, E.; Dessaux, Y. A critical examination of the specificity of the salkowski reagent for indolic compounds produced by phytopathogenic bacteria. Appl. Environ. Microbiol. 1995, 61, 793–796. [Google Scholar] [CrossRef]
- Broughton, W.J.; Dilworth, M.J. Control of leghaemoglobin synthesis in snake beans. Biochem. J. 1971, 125, 1075–1080. [Google Scholar] [CrossRef]
- Weisburg, W.G.; Barns, S.M.; Pelletier, D.A.; Lane, D.J. 16S ribosomal DNA amplification for phylogenetic study. J. Bacteriol. 1991, 173, 697–703. [Google Scholar] [CrossRef]
- National Center for Biotechnology Information (NCBI). Bethesda (MD): National Library of Medicine (US), National Center for Biotechnology Information. 1988. Available online: https://www.ncbi.nlm.nih.gov/ (accessed on 2 March 2022).
- Larkin, M.A.; Blackshields, G.; Brown, N.P.; Chenna, R.; McGettigan, P.A.; McWilliam, H.; Valentin, F.; Wallace, I.M.; Wilm, A.; Lopez, R.; et al. Clustal W and Clustal X version 2.0. Bioinformatics 2007, 23, 2947–2948. [Google Scholar] [CrossRef]
- Saitou, N.; Nei, M. The neighbor-joining method: A new method for reconstructing phylogenetic trees. Mol. Biol. Evol. 1987, 4, 406–425. [Google Scholar] [CrossRef] [PubMed]
- Hawkins, J.P.; Oresnik, I.J. The Rhizobium-Legume Symbiosis: Co-opting Successful Stress Management. Front. Plant Sci. 2022, 12, 796045. [Google Scholar] [CrossRef] [PubMed]
- Couzigou, J.-M.; Zhukov, V.; Mondy, S.; Abu El Heba, G.; Cosson, V.; Ellis, T.H.N.; Ambrose, M.; Wen, J.; Tadege, M.; Tikhonovich, I.; et al. NODULE ROOT and COCHLEATA Maintain Nodule Development and Are Legume Orthologs of Arabidopsis BLADE-ON-PETIOLE Genes. Plant Cell 2012, 24, 4498–4510. [Google Scholar] [CrossRef] [PubMed]
- Zhang, Y.F.; Wang, E.T.; Tian, C.F.; Wang, F.Q.; Han, L.L.; Chen, W.F. Bradyrhizobium elkanii, Bradyrhizobium yuanmingenseandBradyrhizobium japonicumare the main rhizobia associated withVigna unguiculataandVigna radiatain the subtropical region of China. FEMS Microbiol. Lett. 2008, 285, 146–154. [Google Scholar] [CrossRef]
- Frankowski, K.; Wilmowicz, E.; Kućko, A.; Zienkiewicz, A.; Zienkiewicz, K.; Kopcewicz, J. Molecular cloning of the BLADE-ON-PETIOLE gene and expression analyses during nodule development in Lupinus luteus. J. Plant Physiol. 2015, 179, 35–39. [Google Scholar] [CrossRef]
- Faessel, L.; Nassr, N.; Lebeau, T.; Walter, B. Chemically-induced resistance on soybean inhibits nodulation and mycorrhization. Plant Soil 2010, 329, 259–268. [Google Scholar] [CrossRef]
- Othman, H.; Tamimi, S.M. Characterization of rhizobia nodulating faba bean plants isolated from soils of Jordan for plant growth promoting activities and N2 fixation potential. Int. J. Adv. Res. Biol. Sci. 2012, 3, 20–27. [Google Scholar]
- Lin, M.-H.; Gresshoff, P.M.; Ferguson, B. Systemic Regulation of Soybean Nodulation by Acidic Growth Conditions. Plant Physiol. 2012, 160, 2028–2039. [Google Scholar] [CrossRef]
- Appunu, C.; Dhar, B. Symbiotic effectiveness of acid-tolerant Bradyrhizobium strains with soybean in low pH soil. Afr. J. Biotechnol. 2006, 5, 842–845. [Google Scholar]
- García-Fraile, P.; Menéndez, E.; Rivas, R. Role of bacterial biofertilizers in agriculture and forestry. AIMS Bioeng. 2015, 2, 183–205. [Google Scholar] [CrossRef]
- DDe Meyer, S.E.; De Beuf, K.; Vekeman, B.; Willems, A. A large diversity of non-rhizobial endophytes found in legume root nodules in Flanders (Belgium). Soil Biol. Biochem. 2015, 83, 1–11. [Google Scholar] [CrossRef]
- López-López, A.; Rogel, M.A.; Ormeño-Orrillo, E.; Martinez-Romero, J.C.; Martínez-Romero, E. Phaseolus vulgaris seed-borne endophytic community with novel bacterial species such as Rhizobium endophyticum sp. nov. Syst. Appl. Microbiol. 2010, 33, 322–327. [Google Scholar] [CrossRef] [PubMed]
- Yates, R.J.; Howieson, J.G.; Hungria, M. Authentication of rhizobia and assessment of the legume symbiosis in controlled plant growth systems. In Working with Rhizobia; Howieson, J.G., Dilworth, M.J., Eds.; Australian Centre for International Agricultural Research: Canberra, Australia, 2016; pp. 73–108. [Google Scholar]
- Aguilar-Cuba, Y.; Lobo, D.; Ormeño-Orrillo, E.; Zúñiga-Dávila, D. Exploring the potential of three Rhizobium strains from Peruvian soils as biofertilizer for the common bean (Phaseolus vulgaris). In Proceedings of the FAO Keep Soil Alive, Protect Soil Biodiversity—Global Symposium on Soil Biodiversity, Rome, Italy, 19–22 April 2021; pp. 831–837. [Google Scholar] [CrossRef]
- Tarekegn, Y.; Bekele, B.; Tewodros, A.; Yoseph, T.; Baraso, B.; Ayalew, T. Influence of Bradyrhizobia inoculation on growth, nodulation and yield performance of cowpea varieties. Afr. J. Agric. Res. 2017, 12, 1906–1913. [Google Scholar] [CrossRef][Green Version]
- Verbon, E.H.; Liberman, L.M. Beneficial Microbes Affect Endogenous Mechanisms Controlling Root Development. Trends Plant Sci. 2016, 21, 218–229. [Google Scholar] [CrossRef]
- Memenza, M.; Mostacero, E.; Camarena, F.; Zúñiga, D. Disease control and plant growth promotion (PGP) of selected bacterial strains in Phaseolus vulgaris. In Biological nitrogen fixation and Beneficial Plant-Microbe Interactions; González-Andrés, F., James, E., Eds.; Springer International Publishing: Cham, Switzerland, 2016; pp. 237–245. [Google Scholar] [CrossRef]
- Gopalakrishnan, S.; Sathya, A.; Vijayabharathi, R.; Varshney, R.K.; Gowda, C.L.; Krishnamurthy, L. Plant growth promoting rhizobia: Challenges and opportunities. 3 Biotech 2015, 5, 355–377. [Google Scholar] [CrossRef]
- deAraujo, A.S.F.; Lopes, A.C.D.A.; Teran, J.C.B.M.Y.; Palkovic, A.; Gepts, P. Nodulation ability in different genotypes of Phaseolus lunatus by rhizobia from California agricultural soils. Symbiosis 2017, 73, 7–14. [Google Scholar] [CrossRef]
- Franzini, V.I.; Azcón, R.; Méndes, F.L.; Aroca, R. Different interaction among Glomus and Rhizobium species on Phaseolus vulgaris and Zea mays plant growth, physiology and symbiotic development under moderate drought stress conditions. Plant Growth Regul. 2013, 70, 265–273. [Google Scholar] [CrossRef]
- Ahmed, F.E. Interactive effect of nitrogen fertilization and Rhizobium inoculation on nodulation and yield of soybean (Glycine max L. Merrill). Glob. J. Biol. A. 2013, 2, 169–173. [Google Scholar]
- Lamz Piedra, A.; Cárdenas Travieso, R.M.; Ortiz Pérez, R. Evaluation of agro-morphological behavior based on the variability characterization of common bean (Phaseolus vulgaris L.) lines for late sowings. Cultiv. Trop. 2016, 37, 108–114. [Google Scholar]

| Soil | Kind of Soil | Zone | pH (1:1) | E.C. (1:1) dS/m | O.M.% | N% 5% of O.M. | P ppm | K ppm | Texture | Description |
|---|---|---|---|---|---|---|---|---|---|---|
| A2 | Non-rhizospheric | Villa Rica | 3.51 | 0.53 | 3.64 | 0.182 | 5.5 | 95 | Loam | Very strongly acidic and non-saline soil, moderate organic matter content |
| A3 | Non-rhizospheric | Chanchamayo | 5.76 | 0.33 | 2.19 | 0.1095 | 6.1 | 133 | Sandy loam | Moderately acidic and non-saline soil, moderate organic matter content |
| B1 | Rhizospheric | Chanchamayo | 4.74 | 0.77 | 1.86 | 0.093 | 6.5 | 113 | Sandy loam | Strongly acidic and non-saline soil, low organic matter content |
| B2 | Rhizospheric | Villa Rica | 3.43 | 0.86 | 3.91 | 0.1955 | 28 | 108 | Loam | Very strongly acidic and non-saline soil, moderate organic matter content |
| B3 | Rhizospheric | Chanchamayo | 5.75 | 4.78 | 3.31 | 0.1655 | 25 | 1323 | Sandy loam | Moderately acidic and strongly saline soil, moderate organic matter content |
| C | Uncultivated | Chanchamayo | 6.5 | 0.96 | 3.24 | 0.162 | 28 | 160 | Sandy loam | Weakly acidic and weakly saline soil, moderate organic matter content |
| Soil | Pink | White | Root | Shoot | Root Fresh | Shoot Fresh | Root Dry | Shoot Dry | N° | Floral | ||||||||||
|---|---|---|---|---|---|---|---|---|---|---|---|---|---|---|---|---|---|---|---|---|
| Nodules | Nodules | Length (cm) | Length (cm) | Weight (g) | Weight (g) | Weight (g) | Weight (g) | Leaves | Buttons | |||||||||||
| A2 | 0 | c | 0 | c | 12.83 ± 3.31 | b | 38.83 ± 5.38 | bc | 0.69 ± 0.25 | bc | 3.01 ± 0.55 | bc | 0.068 ± 0.03 | a | 0.275 ± 0.06 | bc | 2.67 ± 0.52 | b | 2 ± 1.67 | bc |
| A3 | 3.67 ± 2.25 | b | 7.5 ± 3.62 | a | 14.17 ± 2.02 | ab | 41.5 ± 9.85 | ab | 0.87 ± 0.16 | ab | 3.07 ± 0.7 | bc | 0.068 ± 0.02 | a | 0.262 ± 0.04 | bc | 3.33 ± 0.52 | ab | 2.83 ± 2.56 | bc |
| B1 | 14.67 ± 8.51 | a | 6.67 ± 4.16 | ab | 14.5 ± 0.5 | ab | 52.33 ± 8.15 | a | 1.09 ± 0.41 | a | 4.24 ± 1.53 | a | 0.077 ± 0.02 | a | 0.42 ± 0.16 | a | 3.67 ± 0.58 | a | 2.0817 | a |
| B2 | 0 | bc | 0 | c | 8.33 ± 0.76 | c | 26.83 ± 3.55 | c | 0.5 ± 0.02 | c | 2.45 ± 0.08 | c | 0.04 | b | 0.217 ± 0.01 | c | 2.67 ± 0.58 | b | 1 ± 1 | c |
| B3 | 3 ± 2.97 | bc | 11.5 ± 5.39 | a | 16.17 ± 1.6 | a | 44.83 ± 8.95 | ab | 0.96 ± 0.15 | a | 3.85 ± 0.7 | ab | 0.07 ± 0.06 | a | 0.217 ± 0.06 | abc | 3.33 ± 0.52 | ab | 4.5 ± 1.76 | ab |
| C | 0 | c | 2.17 ± 2.48 | bc | 14.42 ± 3.02 | ab | 45.5 ± 11.93 | ab | 0.98 ± 0.2 | a | 3.98 ± 0.69 | a | 0.063 ± 0.02 | ab | 0.217 ± 0.08 | abc | 3.83 ± 0.75 | a | 3.67 ± 2.58 | abc |
| Strain | Dicalcium Phosphate Solubilization | Tricalcium Phosphate Solubilization | Hydroxyapatite Phosphate Solubilization | IAA (ppm) |
|---|---|---|---|---|
| RSE a | RSE | RSE | ||
| RZC1 | 36% ± 2.51 | 17% ± 1.3 | 70% ± 2.37 abc | 30.4 ± 0.45 |
| RZC2 | 20% ± 4.31 | 10% ± 1.86 | 33% ± 2.99 bcd | 30.6 ± 0.16 |
| RZC3 | 27% ± 2.32 | 15% ± 2.6 | 55% ± 3.71 d | 18.9 ± 0.46 |
| RZC4 | 20% ± 1.91 | 17% ± 1.51 | 30% ± 6.48 bcd | 25.4 ± 0.29 |
| RZC5 | 25% ± 1.84 | 17% ± 3.91 | 40% ± 5.54 a | 30.3 ± 0.14 |
| RZC6 | 36% ± 4.72 | 17% ± 0.57 | 44% ± 6.27 bc | 38.4 ± 0.09 |
| RZC10 | 40% ± 2.23 | 0% | 30% ± 0.72 a | 20.2 ± 0.15 |
| RZC12 | 33% ± 3.33 | 15% ± 0.55 | 45% ± 2.28 cd | 48.9 ± 0.21 |
| RZC13 | 30% ± 2.41 | 9% ± 2.02 | 33% ± 4.18 bcd | 33.9 ± 0.36 |
| RZC17 | 23% ± 2.7 | 15% ± 1.24 | 23% ± 1.89 ab | 41.4 ± 0.44 |
| RZC18 | 23% ± 0.4 | 15% ± 3.9 | 42% ± 4.84 cd | 23.6 ± 0.2 |
| Treat. | N° White Nodules | N° Pink Nodules | Root Length (cm) | Shoot Length (cm) | N° Leaves | Root Fresh Weight (g) | Shoot Fresh Weight (g) | Root Dry Weight (g) | Shoot Dry Weight (g) | |||||||
|---|---|---|---|---|---|---|---|---|---|---|---|---|---|---|---|---|
| Control | 0 | d | 0 | d | 13.3 ± 3.84 | 24.9 ± 3.12 | ab | 4 ± 0.58 | 0.808 ± 0.06 | d | 1.295 ± 0.13 | d | 0.061 ± 0.02 | c | 0.15 ± 0.03 | b |
| N+ | 0 | d | 0 | d | 13.8 ± 1.94 | 26.9 ± 0.33 | a | 4 | 1.228 ± 0.25 | ab | 2.295 ± 0.36 | a | 0.083 ± 0.015 | b | 0.281 ± 0.07 | a |
| RZC1 | 17.3 ± 6.11 | a | 2 ± 1.91 | bcd | 11.8 ± 1.72 | 26.7 ± 4.7 | a | 3 | 1.15 ± 0.13 | abc | 1.773 ± 0.43 | bcd | 0.081 ± 0.013 | bc | 0.225 ± 0.03 | ab |
| RZC2 | 10.5 ± 3.42 | ab | 1 ± 0.82 | cd | 12.2 ± 1.5 | 25.3 ± 1.43 | ab | 3 ± 0.5 | 1.098 ± 0.22 | abc | 1.998 ± 0.4 | abc | 0.082 ± 0.01 | b | 0.261 ± 0.06 | a |
| RZC3 | 14.2 ± 5.40 | ab | 0 | d | 13.2 ± 2.81 | 24.7 ± 2.4 | ab | 3 ± 0.89 | 1.018 ± 0.1 | c | 1.838 ± 0.47 | bcd | 0.082 ± 0.01 | b | 0.234 ± 0.08 | a |
| RZC4 | 5 ± 3.92 | cd | 0 | d | 13.8 ± 1.45 | 22.2 ± 2.89 | b | 3 ± 0.96 | 1.098 ± 0.27 | abc | 1.72 ± 0.33 | cd | 0.083 ± 0.04 | b | 0.212 ± 0.07 | ab |
| RZC5 | 7.2 ± 7.36 | bcd | 0 | d | 13.7 ± 2.55 | 26.8 ± 3.04 | a | 3 ± 1 | 0.994 ± 0.2 | cd | 2.004 ± 0.61 | d | 0.073 ± 0.02 | bc | 0.257 ± 0.1 | a |
| RZC6 | 18 ± 10.15 | a | 1 ± 1.73 | cd | 11.8 ± 0.29 | 26.7 ± 0.85 | a | 4 ± 0.58 | 1.153 ± 0.23 | abc | 2.03 ± 1.98 | abc | 0.081 ± 1.98 | bc | 0.262 ± 0.05 | a |
| RZC10 | 13.3 ± 5.51 | cd | 0.7 ± 1.16 | cd | 13.2 ± 1.02 | 26.2 ± 2.47 | a | 3 | 1.02 ± 0.14 | bcd | 1.83 ± 0.33 | abc | 0.075 ± 0.004 | bc | 0.207 ± 0.01 | ab |
| RZC12 | 18 ± 4.24 | abc | 10.5 ± 8.89 | a | 13.7 ± 3.54 | 26.8 ± 1.49 | a | 4 | 1.288 ± 0.15 | a | 2.213 ± 0.30 | abc | 0.105 ± 0.02 | a | 0.281 ± 0.08 | a |
| RZC13 | 7.8 ± 3.22 | bcd | 4.5 ± 6.61 | bcd | 13.5 ± 1.31 | 25.2 ± 3.6 | ab | 4 ± 0.5 | 1.18 ± 0.15 | abc | 1.855 ± 0.11 | abc | 0.082 ± 0.01 | b | 0.227 ± 0.02 | ab |
| RZC17 | 15.8 ± 11.01 | a | 5.2 ± 1 | b | 13.3 ± 1.5 | 26.9 ± 3.29 | a | 3 ± 0.55 | 1.262 ± 0.21 | a | 2.108 ± 0.37 | abc | 0.083 ± 0.02 | b | 0.272 ± 0.08 | a |
| RZC18 | 10.3 ± 8.08 | abc | 0.7 ± 0.58 | cd | 12.3 ± 2.8 | 26.7 ± 3.05 | a | 3 ± 1.16 | 1.233 ± 0.14 | ab | 2.187 ± 0.26 | abc | 0.081 ± 0.02 | bc | 0.273 ± 0.045 | a |
| Treatment | Shoot Length (cm) | Root Length (cm) | N° Leaves | N° Flowers | N° Pots | N° Nodules | Shoot Fresh Weight (g) | Root Fresh Weight (g) | Shoot Dry Weight (g) | Root Dry Weight (g) | ||
|---|---|---|---|---|---|---|---|---|---|---|---|---|
| RZC12 | 41.77 ± 4.92 | a | 22.63 ± 3.88 | 5.86 ± 0.69 | 3 ± 0.82 | 1.43 ± 0.53 | 26.43 ± 7.72 | a | 4.04 ± 0.65 | 2.5 ± 0.48 | 2.42 ± 0.56 | 0.28 ± 0.06 |
| RZC17 | 40.04 ± 4.05 | a | 20.36 ± 4.4 | 60.82 ± 4.39 | 3.29 ± 0.76 | 1.43 ± 0.53 | 18.71 ± 5.59 | b | 3.85 ± 0.29 | 2.53 ± 047 | 2.72 ± 0.48 | 0.25 ± 0.03 |
| CONTROL | 34.7 ± 3.02 | b | 19.27 ± 3.02 | 5.57 ± 0.53 | 3 ± 0.82 | 1.29 ± 0.49 | 1.57 ± 1.27 | c | 3.32 ± 0.6 | 2.19 ± 0.41 | 2.24 ± 0.46 | 0.23 ± 0.03 |
| Treat. | Shoot Length (cm) | Root Length (cm) | N° Leaves | N° Flowers | N° Nodules | Shoot Fresh Weight (g) | Root Fresh Weight (g) | Pod Fresh Weight (g) | Shoot Dry Weight (g) | Root Dry Weight (g) | Pod Dry Weight (g) | |||||||||
|---|---|---|---|---|---|---|---|---|---|---|---|---|---|---|---|---|---|---|---|---|
| RZC12 | 33.59 ± 4.34 | a | 15.31 ± 3.23 | 5.4 ± 0.97 | a | 3.3 ± 0.68 | 21 ± 8.68 | a | 8.44 ± 2.48 | a | 1.62 ± 0.51 | a | 5.68 ± 0.92 | a | 4.27 ± 2.48 | a | 0.182 ± 1.3 | a | 3.8 ± 0.67 | a |
| CONTROL | 19.45 ± 1.85 | b | 13.5 ± 3.58 | 3.4 ± 0.7 | b | 2.8 ± 0.79 | 0.7 ± 1.06 | b | 4.55 ± 1.15 | b | 0.91 ± 0.17 | b | 4.16 ± 1.23 | b | 2.3 ± 1.15 | b | 0.116 ± 0.58 | b | 2.36 ± 0.63 | b |
Publisher’s Note: MDPI stays neutral with regard to jurisdictional claims in published maps and institutional affiliations. |
© 2022 by the authors. Licensee MDPI, Basel, Switzerland. This article is an open access article distributed under the terms and conditions of the Creative Commons Attribution (CC BY) license (https://creativecommons.org/licenses/by/4.0/).
Share and Cite
Lirio-Paredes, J.; Ogata-Gutiérrez, K.; Zúñiga-Dávila, D. Effects of Rhizobia Isolated from Coffee Fields in the High Jungle Peruvian Region, Tested on Phaseolus vulgaris L. var. Red Kidney. Microorganisms 2022, 10, 823. https://doi.org/10.3390/microorganisms10040823
Lirio-Paredes J, Ogata-Gutiérrez K, Zúñiga-Dávila D. Effects of Rhizobia Isolated from Coffee Fields in the High Jungle Peruvian Region, Tested on Phaseolus vulgaris L. var. Red Kidney. Microorganisms. 2022; 10(4):823. https://doi.org/10.3390/microorganisms10040823
Chicago/Turabian StyleLirio-Paredes, Jesus, Katty Ogata-Gutiérrez, and Doris Zúñiga-Dávila. 2022. "Effects of Rhizobia Isolated from Coffee Fields in the High Jungle Peruvian Region, Tested on Phaseolus vulgaris L. var. Red Kidney" Microorganisms 10, no. 4: 823. https://doi.org/10.3390/microorganisms10040823
APA StyleLirio-Paredes, J., Ogata-Gutiérrez, K., & Zúñiga-Dávila, D. (2022). Effects of Rhizobia Isolated from Coffee Fields in the High Jungle Peruvian Region, Tested on Phaseolus vulgaris L. var. Red Kidney. Microorganisms, 10(4), 823. https://doi.org/10.3390/microorganisms10040823

